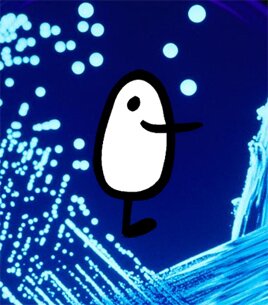
BiotecUV's profile picture. Cuenta creada por estudiantes del grado de  Biotecnología de la UV. Respondemos a vuestras dudas desde la experiencia de estos años de carrera.

Blast2GO
@blast2go
I am a one-stop bioinformatics solution for functional genomics research
You might like
What a great picture!!! Thanks to all participants for the hard work, the many ideas and the strong @i2sysbio spirit 😍
#FirstI2SysBioRetreat Intensive day of work and teambuilding, discussing new ideas and ambitious plans to improve & face the challenges ahead #ElMolinar @CsicLifehub @CSICval @UV_EG @EmiliaMatallana @SantiagoFElena @anaconesa @pilardomingoc @Otero_Muras @_carlarubio @CPicam

We arrived to Sitges!!! It has been 350 km since we left Valencia 3 days ago! We are so glad we made it!! Thanks to @bio_bam for sponsoring this trip! Looking now forward to #ECC2022 and #ESCS22 #sustainableConferenceTravel @ISMBinfo @iscbsc @i2sysbio



Please follow also our other accounts where we will be making all future announcements for OmicsBox, the Blast2GO successor. Twitter: bit.ly/2WNURQi - Facebook: bit.ly/2ZmnzcJ - Linkedin: bit.ly/2Xj5ZUo #omicsbox @bio_bam #bioinformatics #genomics

Please follow also our other accounts where we will be making all future announcements for OmicsBox, the Blast2GO successor. Twitter: bit.ly/2WNURQi - Facebook: bit.ly/2ZmnzcJ - Linkedin: bit.ly/2Xj5ZUo #omicsbox @bio_bam #bioinformatics #genomics

Please follow also our other accounts where we will be making all future announcements for OmicsBox, the Blast2GO successor. Twitter: bit.ly/2WNURQi - Facebook: bit.ly/2ZmnzcJ - Linkedin: bit.ly/2Xj5ZUo #omicsbox @bio_bam #bioinformatics #genomics

Please follow also our other accounts where we will be making all future announcements for OmicsBox, the Blast2GO successor. Twitter: bit.ly/2WNURQi - Facebook: bit.ly/2ZmnzcJ - Linkedin: bit.ly/2Xj5ZUo #omicsbox @bio_bam #bioinformatics #genomics

Please follow also our other accounts where we will be making all future announcements for OmicsBox, the Blast2GO successor. Twitter: bit.ly/2WNURQi - Facebook: bit.ly/2ZmnzcJ - Linkedin: bit.ly/2Xj5ZUo #omicsbox @bio_bam #bioinformatics #genomics

Please follow also our other accounts where we will be making all future announcements for OmicsBox, the Blast2GO successor. Twitter: bit.ly/2WNURQi - Facebook: bit.ly/2ZmnzcJ - Linkedin: bit.ly/2Xj5ZUo #omicsbox @bio_bam #bioinformatics #genomics

Please follow also our other accounts where we will be making all future announcements for OmicsBox, the Blast2GO successor. Twitter: bit.ly/2WNURQi - Facebook: bit.ly/2ZmnzcJ - Linkedin: bit.ly/2Xj5ZUo #omicsbox @bio_bam #bioinformatics #genomics

Please follow also our other accounts where we will be making all future announcements for OmicsBox, the Blast2GO successor. Twitter: bit.ly/2WNURQi - Facebook: bit.ly/2ZmnzcJ - Linkedin: bit.ly/2Xj5ZUo #omicsbox @bio_bam #bioinformatics #genomics

Please follow also our other accounts where we will be making all future announcements for OmicsBox, the Blast2GO successor. Twitter: bit.ly/2WNURQi - Facebook: bit.ly/2ZmnzcJ - Linkedin: bit.ly/2Xj5ZUo #omicsbox @bio_bam #bioinformatics #genomics

Please follow also our other accounts where we will be making all future announcements for OmicsBox, the Blast2GO successor. Twitter: bit.ly/2WNURQi - Facebook: bit.ly/2ZmnzcJ - Linkedin: bit.ly/2Xj5ZUo #omicsbox @bio_bam #bioinformatics #genomics

Please follow also our other accounts where we will be making all future announcements for OmicsBox, the Blast2GO successor. Twitter: bit.ly/2WNURQi - Facebook: bit.ly/2ZmnzcJ - Linkedin: bit.ly/2Xj5ZUo #omicsbox @bio_bam #bioinformatics #genomics

Please follow also our other accounts where we will be making all future announcements for OmicsBox, the Blast2GO successor. Twitter: bit.ly/2WNURQi - Facebook: bit.ly/2ZmnzcJ - Linkedin: bit.ly/2Xj5ZUo #omicsbox @bio_bam #bioinformatics #genomics

Please follow also our other accounts where we will be making all future announcements for OmicsBox, the Blast2GO successor. Twitter: bit.ly/2WNURQi - Facebook: bit.ly/2ZmnzcJ - Linkedin: bit.ly/2Xj5ZUo #omicsbox @bio_bam #bioinformatics #genomics

Please follow also our other accounts where we will be making all future announcements for OmicsBox, the Blast2GO successor. Twitter: bit.ly/2WNURQi - Facebook: bit.ly/2ZmnzcJ - Linkedin: bit.ly/2Xj5ZUo #omicsbox @bio_bam #bioinformatics #genomics

Loved to see the evaluation of the sugarcane @PacBio Sequel I and II transcriptome done with @blast2go 😍More GO terms and annotation success with Sequel II. Advice: use #SQANTI curation of your transcripts too!!! #PAG2020 #PAGXXVIIII
Bang! we containerized another graphical app and added it to our Databiology Hub which already includes hundreds of biomedical apps! @blast2go is now available for use in Databiology Lab. Sign up today! tinyurl.com/databiology-si… #functionalgenomics #geneannotation #FAIRapps

OmicsBox v.1.1 released. Features new assembly and alignment tools. Read our blog: biobam.com/blog/ #bioinformatics #software #transcriptomics #rnaseq #dnaseq #omicsbox

Workshop: Our RNA-Seq Data Analysis Course in Seville, Spain was a great success and we hope to repeat soon. training.biobam.com #bioinformatics #training #workshop #transcriptomics #rnaseq #omicsbox #blast2go

United States Trends
- 1. Wemby 33.7K posts
- 2. Steph 71.3K posts
- 3. Spurs 31.6K posts
- 4. Draymond 14.1K posts
- 5. Clemson 11.2K posts
- 6. Louisville 10.9K posts
- 7. #SmackDown 51.6K posts
- 8. Zack Ryder 16K posts
- 9. Harden 14.4K posts
- 10. Aaron Fox 2,276 posts
- 11. #DubNation 2,031 posts
- 12. Massie 55.6K posts
- 13. Marjorie Taylor Greene 46.6K posts
- 14. Brohm 1,667 posts
- 15. Dabo 1,988 posts
- 16. Bill Clinton 187K posts
- 17. Landry Shamet 5,948 posts
- 18. Mitch Johnson N/A
- 19. Matt Cardona 2,909 posts
- 20. UCLA 8,692 posts
Something went wrong.
Something went wrong.